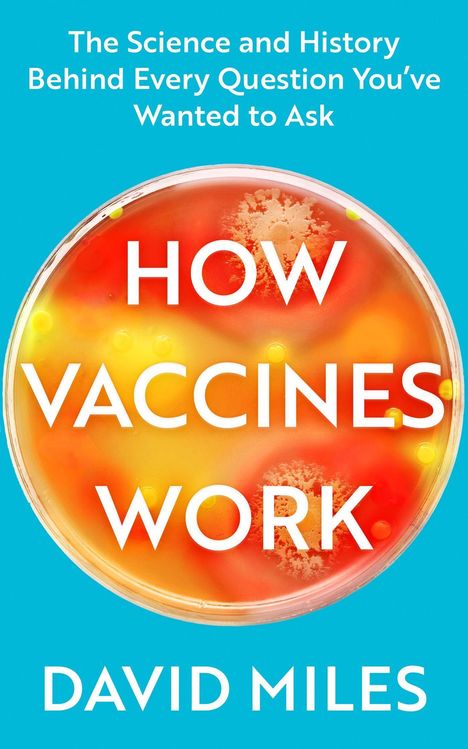

David Miles: How Vaccines Work, Kartoniert / Broschiert
How Vaccines Work
Buch
- The Science and History Behind Every Question You've Wanted to Ask
Erscheint bald
Lassen Sie sich über unseren eCourier benachrichtigen, sobald das Produkt bestellt werden kann.
Lassen Sie sich über unseren eCourier benachrichtigen, sobald das Produkt bestellt werden kann.
- Verlag:
- Little, Brown Book Group, 01/2030
- Einband:
- Kartoniert / Broschiert
- Sprache:
- Englisch
- ISBN-13:
- 9780349428895
- Umfang:
- 480 Seiten
- Erscheinungstermin:
- 1.1.2030
- Hinweis
-
Achtung: Artikel ist nicht in deutscher Sprache!